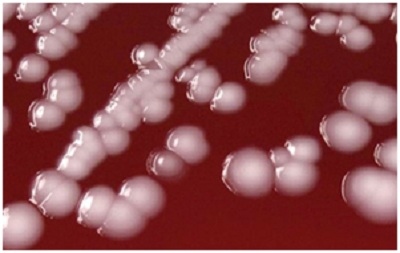

12 loại vi khuẩn kháng thuốc gây chết người được WHO công bố
Song hành với những bước tiến vượt bậc và thành tựu đã đạt được trong y khoa, một thách thức khác vô cùng lớn đối với nhân loại là 12 loại vi khuẩn kháng thuốc gây chết người vừa được Tổ chức Y tế Thế giới (WHO) công bố.
Đánh giá chung
12 loại vi khuẩn nguy hiểm đã phát triển khả năng đề kháng với các loại thuốc dùng trong điều trị các bệnh lây nhiễm thông thường và cướp đi sinh mạng của 700.000 người mỗi năm. Nếu tình trạng này vẫn tiếp tục diễn tiến, các chuyên gia dự đoán: Trước năm 2050, số người thiệt mạng sẽ tăng lên 10 triệu người mỗi năm.
Marie-Paule Kieny - trợ lý Tổng giám đốc trong lĩnh vực hệ thống y tế và đổi mới của WHO, phát biểu"Vi khuẩn kháng thuốc đang gia tăng với tốc độ chóng mặt và chúng ta phải nhanh chóng tìm ra các biện pháp chữa trị phù hợp. Nếu tình trạng này cứ tiếp diễn, chúng ta sẽ không thể chế tạo ra các loại thuốc chữa bệnh kịp thời”.
Mức độ nguy hiểm chia thành ba loại
Dựa vào mức độ nguy hiểm, danh sách này được chia thành ba loại: trầm trọng, cao và trung bình. Kết quả xếp loại cho thấy sự cấp bách trong việc tìm ra các loại thuốc tương ứng để điều trị các siêu khuẩn.
Mức độ trầm trọng bao gồm ba vi khuẩn: Acinetobacter baumannii, Pseudomonas aeruginosa và Enterobacteriaceae. Những vi khuẩn này kháng được rất nhiều loại thuốc và có thể gây ra một loạt các bệnh nhiễm trùng nghiêm trọng, bao gồm viêm phổi và nhiễm trùng máu.Chúng được gọi là vi khuẩn gram âm, thường sống trong ruột đã phát triển hai màng tế bào. Chính vì điều này mà các phân tử thuốc rất khó để xâm nhập vào.
Nhà nghiên cứu kháng sinh Carolyn Shore phát biểu trên CBC News "Nếu các phân tử thuốc không lọt được vào bên trong tế bào, nó không thể hoạt động và tiêu diệt vi khuẩn".
Chín tác nhân gây bệnh khác xếp ở mức độ nguy hiểm cao và trung bình là các vi khuẩn gây ra các bệnh phổ biến hơn, chẳng hạn như bệnh lậu và ngộ độc thực phẩm. Đây là các bệnh có thể gây chết người, và đang ngày càng trở nên kháng thuốc. Chúng bao gồm Staphylococcus aureus kháng methicillin (MRSA), salmonellae, và Helicobacter pylori (gây viêm loét dạ dày tá tràng).

Danh sách này là lời cảnh báo của WHO về tình trạng kháng thuốc nghiêm trọng đang diễn ra. Những nỗ lực nghiên cứu và phát triển thuốc hiện nay vẫn chưa đủ để kiềm chế sự phát triển của các loại siêu khuẩn.
Việc công bố kết quả nghiên cứu “không phải để hù dọa mọi người về các siêu khuẩn mới, mà là để báo hiệu cho các nhà nghiên cứu và các công ty dược nên điều chỉnh lại thứ tự ưu tiên của họ", Kieny nói với giới truyền thông tại một cuộc họp báo ở Geneva, Thụy Sĩ.
Theo Kienny, các công ty dược phẩm không kiếm được nhiều lợi nhuận trong việc sản xuất thuốc kháng sinh. Vấn đề này làm giảm động cơ nghiên cứu và phát triển các loại thuốc mới của họ.
Giải pháp
Việc nghiên cứu và phát triển thuốc kháng sinh tốn một số tiền rất lớn nhưng nó chỉ được các bệnh nhân sử dụng trong một thời gian ngắn. Điều đó có nghĩa là chỉ một số lượng nhỏ thuốc được bán ra.
Một giải pháp có thể làm thay đổi cách các công ty và cơ quan nghiên cứu thuốc đó chính là thưởng cho họ. Các phần thưởng này sẽ giúp họ tăng nguồn thu thay vì chỉ có thể tạo ra lợi nhuận thông qua việc bán thuốc – vốn rất ít.
Nhưng để vận hành một hệ thống như vậy, đòi hỏi sự hợp tác chặt chẽ từ các chính phủ trên khắp thế giới. Chuyên gia kháng khuẩn Petra Gastmeier của Đại học Charité ở Đức phát biểu trên Science “Đây không phải là một vấn đề mà chúng ta có thể giải quyết ở cấp quốc gia. Và đây là một trong những ví dụ về sự liên kết của các nước có thu nhập trung bình với các nước có thu nhập cao".
Qua đó, người ta hy vọng rằng, danh sách mới do WHO cung cấp sẽ khiến các quốc gia tập trung hơn vào việc tìm ra các giải pháp chống lại các vi khuẩn có thể gây chết người.Theo Kieny, ước tính các loại thuốc mới có thể được sử dụng trong một thập niên nữa. Bởi vậy, trước thời điểm đó, các nhà nghiên cứu nên chế tạo ra các loại thuốc khác tốt hơn.
Skcs (Theo Sciencealert)
Các tin khác
-
Top 4 loại rau ‘vàng’ thanh nhiệt, hỗ trợ tiêu hóa tốt nhất mùa hè
Mùa hè nắng nóng oi bức khiến cơ thể mệt mỏi, chán ăn, cơ thể đổ mồ hôi nhiều. Đây là giai đoạn tốt nhất để bổ sung những loại rau theo mùa vừa thanh mát, dễ tiêu hóa, thanh nhiệt cơ thể lại giàu dinh dưỡng cho cả gia đình trong mùa hè này. -
5 Loại cá mùa hè giá bình dân giúp bổ não, sáng mắt
Cá từ lâu đã là nguồn thực phẩm tốt cho sức khỏe nhờ tiêu chí giàu đạm chất lượng cao, ít chất béo xấu và cực kỳ dễ tiêu hóa, khi ăn còn giúp bổ não, sáng mắt, tăng cường miễn dịch cho cơ thể. -
5 loại đồ uống mùa hè mát gan, bổ thận cực tốt
Thay vì lạm dụng các loại nước ngọt chứa nhiều đường, việc bổ sung các loại nước mát tự nhiên là giải pháp tối ưu hơn cả. Hãy cùng khám phá ngay 5 loại đồ uống mùa hè mát gan, bổ thận cực tốt, vừa giúp đập tan cơn khát tức thì, vừa nuôi dưỡng cơ thể khỏe mạnh từ sâu bên trong. -
Bật mí 4 món ăn từ đậu: giúp giảm cân, ổn định đường huyết
Sở dĩ các thực phẩm có nguồn gốc thực vật thuộc họ đậu trở thành trợ thủ đắc lực cho hành trình thon dáng và quản lý sức khỏe, ổn định đường huyết là nhờ sự hiện diện đậm đặc của bộ đôi protein và chất xơ hòa tan. -
Hoạt động thể chất giữ cho trái tim khỏe mạnh, ngay cả khi bạn không giảm cân
Hoạt động thể chất giữ cho trái tim của bạn khỏe mạnh, ngay cả khi bạn không giảm cân. Hiệp hội Tim mạch Hoa Kỳ khuyến cáo tập thể dục thường xuyên giúp cải thiện huyết áp, lượng đường trong máu và mức cholesterol, bất kể có cần giảm cân hay không. -
Nắng nóng mất sức: 5 loại rau giàu kali giúp cơ thể tràn đầy năng lượng
Mùa hè nắng nóng khiến cơ thể luôn mệt mỏi, uể oải do mất nước và khoáng chất. Nếu bạn nghĩ chuối là 'vua kali' giúp hồi phục năng lượng, thì 5 loại rau củ quen thuộc dưới đây sẽ khiến bạn bất ngờ với hàm lượng kali vượt trội hơn hẳn -
3 cách tăng chất xơ trong bữa ăn: đơn giản, ai cũng làm được
Bạn có biết, chỉ cần thay đổi một vài thói quen nhỏ trong thực đơn bạn đã có thể nhân đôi lượng chất xơ nạp vào cơ thể mà không làm thay đổi thực đơn yêu thích? -
Cách uống nước ngày hè gây hại thận: 5 sai lầm cực phổ biến
Việc dung nạp nước sai cách vào mùa hè có thể gây co mạch đột ngột, làm suy giảm chức năng thận và tích tụ độc tố. Bài viết dưới đây sẽ chỉ ra 5 kiểu uống nước sai lầm ngày nắng nóng mà rất nhiều người mắc phải. -
Nắng nóng 7 loại rau củ quả giúp bù điện giải, giảm nóng trong người cực tốt
Hãy cùng khám phá ngay 7 loại rau củ quả mọng nước được ví như những "nhà máy bù điện giải cấp tốc", giúp cả gia đình dập tắt cơn nóng trong và tràn đầy năng lượng suốt mùa hè này. -
Sai lầm ngày hè: 4 thức uống càng uống càng khát, khiến cơ thể mất nước trầm trọng
Giữa cái nắng oi ả của mùa hè uống một lon nước tăng lực mát lạnh, một ly nước ép trái cây nguyên chất 100% hay ly cà phê đá đậm đà là điều yêu thích của nhiều người.
